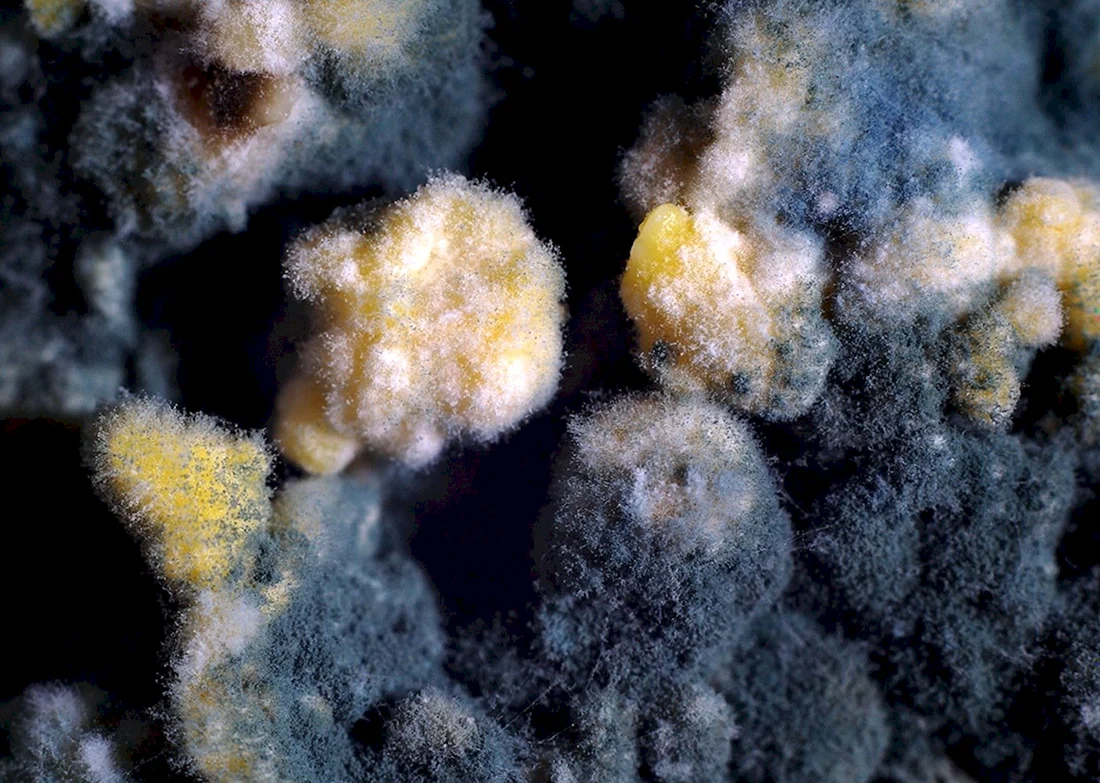

Зеленая плесень Trichoderma
Плесневые грибы Rhizopus
Зеленая плесень пеницилл
Плесневые грибы
Зеленая плесень пеницилл на хлебе
Плесневые грибы аспергиллус
Плесень
Плесень
Плесневые грибы фон
Плесневые грибы бактерии
Плесень
Зеленая плесень пеницилл на хлебе
Плесень пеницилл
Плесень аспергилл черный
Bipolaris плесень
Белая плесень мукор
Плесневые грибы бактерии
Плесень мукор
Плесневые гриб черная плесень
Аспергилл гриб
Bipolaris плесень
Микотоксины плесени
Плесень
Грибница плесени
Pilobolus crystallinus
Плесень
Черная плесень аспергиллус
Живая плесень
Плесневелые грибы
Заплесневелый хлеб
Слизевик Metatrichia
Плесень пенициллиум
Зигомицеты
Слизевик Metatrichia
Плесень мукор на хлебе
Плесень
Грибница плесени
Зеленая плесень пеницилл на хлебе
Белая плесень
Мукор белая плесень гриб
Плесень

Вау, некоторые фотки реально страшные, прям мурашки по коже! А другие как-то даже красиво сделаны… Хотя, понятно, что это не самое приятное зрелище.
Классная подборка картинок, тут реально не все так просто с цветом и текстурой. Не ожидал, что такое можно по-другому увидеть.
Не ожидала, что такой абстрактный мужик-то так зацепил. Круто смотрится, прям как будто какая-то арт-база .